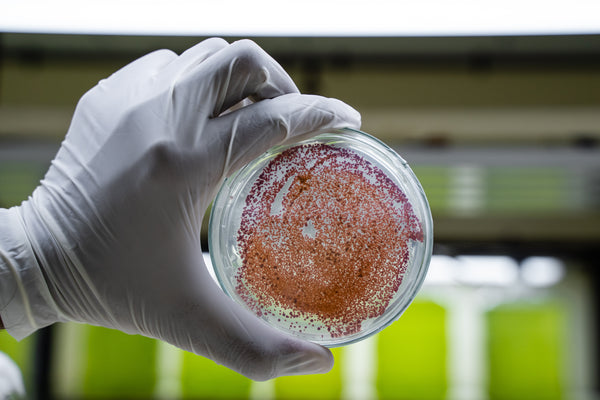

The Soul of Albae™
-

Purpose-built nutrition
Carefully designed formulations that support overall well-being and help address critical nutrient gaps.
-

Science-based benefit you can feel
Patented ingredients backed by 70+ clinical studies and 40,000 scientific publications, delivering results you can trust.
-

Cleaner source. Lower Carbon Footprint
Sustainably sourced nutrition with up to 40% lower carbon footprint compared to traditional marine-derived alternatives.
-

Radical Label Transparency
Clean, high-potency ingredients that are tested for their purity, stability and complete traceability from source to capsule.
Find Your Formula for Daily Wellness
Three simple, clean formulas, each designed to support a different aspect of your health.
Frequently Asked Questions
Why choose algae-based supplements over traditional fish oil?
Algae are the original source of omega-3s, not fish oil. By going directly to algae, you get pure, plant-based nutrition without ocean-borne contaminants, heavy metals, or the environmental cost of overfishing. Algae-based supplements are cleaner, vegan, and more sustainable than fish-derived oils.
How are Albae™ products cleaner and safer than ocean-sourced supplements?
Albae’s microalgae are grown in closed, controlled fermentation tanks, not harvested from the sea. This eliminates exposure to ocean pollutants and ensures every ingredient is clean, traceable, and free from heavy metals or contaminants. Each batch undergoes rigorous testing to meet global purity and safety standards.
What benefits can I expect from algae-based DHA and astaxanthin?
Algae-derived DHA supports cognitive health, brain function, vision, and cellular wellness. Algae-derived Astaxanthin is one of nature’s most powerful antioxidants It helps protect cells from oxidative stress and supports immunity and healthy ageing. Together, they provide clean, plant-based support for daily wellness.
Are Albae™ supplements suitable for vegans, vegetarians, and sensitive consumers?
Yes. Every Albae™ product is 100% vegan and vegetarian, made from algae and plant-based ingredients. We avoid gelatin, fish oil, and other animal-derived compounds and follow clean-label principles, making our supplements suitable for vegans, vegetarians, and those sensitive to common allergens.
What makes Albae™ different from other plant-based supplement brands?
Albae’s difference begins at the source. Algae cultivated in closed, controlled environments, ensuring unmatched purity and consistency. Our science-backed formulations combine algae-based DHA, astaxanthin, vitamins, and minerals in precise ratios for targeted benefits. We bring years of biomanufacturing expertise from Shaivaa Algaetech, creating supplements that are clean, sustainable, and planet-friendly.
What are some natural sources of omega-3 fatty acids?
Plant foods contain the parent Omega-3 fatty acid, ALA (alpha-linolenic acid). Great sources include chia seeds, flaxseeds, hemp seeds, and walnuts. However, the human body is inefficient at converting ALA into the active, brain-essential form, DHA. This is why we recommend our supplements, as they contain ready-to-use DHA directly from vegan algae omega-3 sources, which is the most effective way to ensure you meet your daily needs.